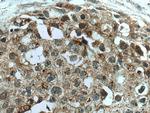
ZFHX3 Antibody in Immunohistochemistry (Paraffin) (IHC (P))

Search
Proteintech
ZFHX3 Polyclonal Antibody
{{$productOrderCtrl.translations['antibody.pdp.commerceCard.promotion.promotions']}}
{{$productOrderCtrl.translations['antibody.pdp.commerceCard.promotion.viewpromo']}}
{{$productOrderCtrl.translations['antibody.pdp.commerceCard.promotion.promocode']}}: {{promo.promoCode}} {{promo.promoTitle}} {{promo.promoDescription}}. {{$productOrderCtrl.translations['antibody.pdp.commerceCard.promotion.learnmore']}}
产品信息
20157-1-AP
种属反应
宿主/亚型
分类
类型
抗原
偶联物
形式
浓度
规格
纯化类型
保存液
内含物
保存条件
运输条件
产品详细信息
Sequence of this protein is as follows: QLVSEELMNL GESFIQTNDP SLKLFQCAVC NKFTTDNLDM LGLHMNVERS LSEDEWKAVM GDSYQCKLCR YNTQLKANFQ LHCKTDKHVQ KYQLVAHIKE GGKANEWRLK CVAIGNPVHL KCNACDYYTN SLEKLRLHTV NSRHEASLKL YKHLQQHESG VEGESCYYHC VLCNYSTKAK LNLIQHVRSM KHQRSESLRK LQRLQKGLPE EDEDLGQIFT IRRCPSTDPE EAIEDVEGPS ETAADPEELA KDQEGGASSS QAEKELTDSP ATSKRISFPG SSESPLSSKR PKTAEEIKPE QMYQCPYCKY SNADVNRLRV HAMTQHSVQP MLRCPLCQDM LNNKIHLQLH
靶标信息
Transcriptional repressor. It inhibits the enhancer element of the AFP gene by binding to its AT-rich core sequence. Regulator of myoblasts differentiation through the binding to the AT-rich sequence of MYF6 promoter and promoter repression. Down-regulates the MUC5AC promoter in gastric cancer. Miura Y., J. Biol. Chem. 270:26840-26848(1995). Morinaga T., Mol. Cell. Biol. 11:6041-6049(1991). Martin J., Nature 432:988-994(2004).
仅用于科研。不用于诊断过程。未经明确授权不得转售。
篇参考文献 (0)
生物信息学
蛋白别名: alpha-fetoprotein enhancer binding protein; Alpha-fetoprotein enhancer-binding protein; AT motif binding factor 1; AT motif-binding factor 1; AT-binding transcription factor 1; unnamed protein product; ZFH-3; Zinc finger homeobox protein 3; Zinc finger homeodomain protein 3
基因别名: A230102L03Rik; ATBF1; ATBT; ATFB8; C16orf47; mKIAA4228; SCA4; WBP9; ZFH-3; ZFHX3; ZNF927
UniProt ID: (Human) Q15911
Entrez Gene ID: (Human) 463, (Mouse) 11906